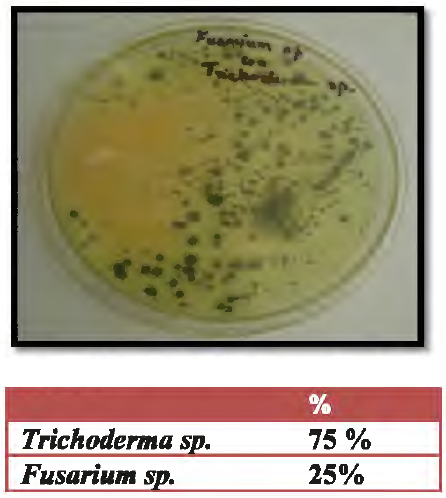
Trichoderma sp. frente al patógeno Fusarium sp.
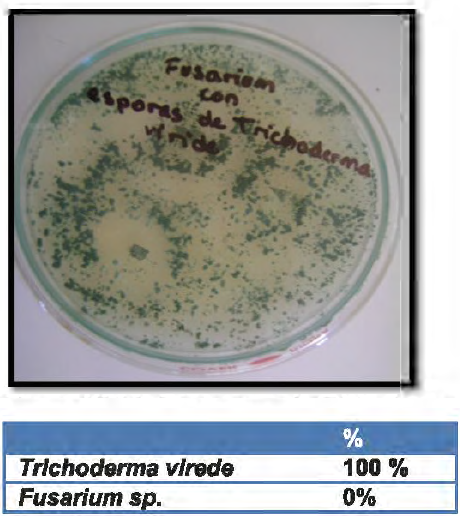
De esporas de Trichoderma viride frente
al patógeno Fusarium sp.

Efecto antagónico de una cepa de Trichoderma sp sobre Fusarium sp. En planta de tomate Río Grande (Solanum lycopersicum)
Antagonistic effect of a Trichoderma sp. Strain over Fusarium sp In a tomato plant Rio Grande (Solanum lycopersicum)
Efecto antagónico de una cepa de Trichoderma sp sobre Fusarium sp. En planta de tomate Río Grande (Solanum lycopersicum)
UCV-HACER. Revista de Investigación y Cultura, vol. 5, núm. 1, pp. 64-68, 2016
Universidad César Vallejo

Esta obra está bajo una Licencia Creative Commons Atribución-NoComercial-CompartirIgual 4.0 Internacional.
Recepción: 10 Marzo 2016
Aprobación: 08 Abril 2016
Publicación: 01 Agosto 2016
Resumen: Fusariosis es una de las principales enfermedades que afectan el cultivo de tomate (Lycopersicon lycopersicum), siendo esta enfermedad causada por varias especies del genero Fusarium como Fusarium oxysporum f. sp. Lycopersici, Fusarium oxysporum f. sp. radicis-lycopersici, y Fusarium solani. En esta investigación se evaluó el efecto antagónico de una cepa de Trichoderma sp., sobre Fusarium sp., en plantas de tomate cultivadas en invernadero; además de comparar la acción biocontroladora de la cepa de Trichoderma sp con una alternativa química de control dada por el fungicida Benomilo y con una formulación comercial de Trichoderma viride. La cepa comercial de Trichoderma viride presentó una alta eficiencia protectora, con un 90% de sobrevivencia de plantas, la cual fue siempre superior a la cepa de Trichoderma sp, que alcanzó al 70% de sobrevivencia. El fungicida benomilo ofreció una amplia protección de las plantas de tomate al ataque del hongo Fusarium sp siendo mayor al ejercido por la cepa Trichoderma viride. Cuando los biocontroladores fueron mezclados con el fungicida benomilo, éste produjo un efecto detrimental en la acción tanto de la cepa Trichoderma sp como de la formulación comercial cepa de Trichoderma viride; siendo mucho más acentuado en este último.
Palabras clave: Fusarium, Trichoderma, tomate, control biológico Fusarium, Trichoderma, tomate, control biológico.
Abstract: Fusarium is one ofthe main illnesses that affect the tomato crop (Lycopersicon lycopersicum) being this illness caused by several species of genre Fusarium como Fusarium oxysporum f. sp. Lycopersici, Fusarium oxysporum f. sp. radicis-lycopersici, y Fusarium solani. In this research the antagonistic effect of a Trichoderma sp. strain was evaluated, over Fusarium sp., in tomato plants cultivated in greenhouse; besides compare the biocontrol action of the Trichoderma sp strain with an alternative of control chemistry given for the fungicide Benomyl and with a commercial formulation of Trichoderma viride. The commercial strain of Trichoderma viride demonstrated a high protectress efficiency, with 90% of plants survival, which was always top to Trichoderma sp strain that reached 70% of survival. The benomyl fungicide offered a wide protection of tomate plants at fungus attack Fusarium sp being bigger exercised by the strain Trichoderma viride. When the bío controls were mixed with the benomyl fungicide, the fungicide produced a detrimental effect in the action as of the strain Trichoderma sp as strain commercial formulation Trichoderma viride; being stronger in this last mentioned.
Keywords: Fusarium, Trichoderma, tomato, Fusarium biologic control, Trichoderma, tomato, biologic control.
Introducción
La marchitez en tomate (Lycopersicon esculentum) causada por Fusarium oxysporum tiene amplia distribución en Venezuela (Urtiaga 1986, Diaz-Polanco y Diaz 1973, Reyes y Sanabria 1997) y el mundo (Jones 1991). El patógeno es un habitante del suelo que también puede diseminarse por semilla (Abdalla et al. 1998).
Los Fusarium causantes de marchitez siguen un patrón similar de infección; penetran por la raíz y colonizan en el tallo de las plantas el sistema vascular (Turlier et al. 1994).
La eficacia de los fungicidas en el control de la marchitez no está comprobada, aunque a nivel in vitro se han obtenido algunos resultados positivos, así como con control biológico (Jiménez y Sanabria 1997 a y b).
La búsqueda de nuevas alternativas de control que complementen la resistencia genética constituye una de las prioridades actuales en el manejo de la enfermedad, el uso de productos naturales es una de las medidas en las que se está haciendo énfasis porque permite un control de la plaga con daños mínimos al ambiente.
Entre los productos naturales, los extractos de plantas han demostrado tener efectos positivos en el control de patógenos foliares y del suelo (Awuah 1994, Lawson et al. 1998, Bower y Locke 2000, Bravo et al. 2000, Guevara et al. 2000).
Por lo tanto se han realizado algunas investigaciones aplicando la acción de hongos antagonistas para el control biológico. El objetivo de este trabajo es la evaluación del efecto antagónico de una cepa de Trichoderma sp. sobre Fusarium sp en plantas de Tomate Río Grande (Solanum lycopersicum).
Materiales y Métodos
Materiales biológicos:
-
- El material que se utilizara son esquejes enraizados de plantas de tomate (Solanum lycopersicum). Hortus
-
- Como patógeno se utilizará Fusarium sp. (aislado de plantas de ají del Distrito de Jayanca)
-
- Hongo antagonista Trichoderma sp (proporcionada por el Laboratorio de Biotecnología y Control Integrado de Plagas - UNPRG) y Trichoderma viride (Senasa - Lima)
Material de vidrio: Placas Petri, Tubos de ensayo, Pipetas, Bickers y Cámara de Neubauer
Equipos: Microscopio, Autoclave, Horno, pHmetro
Reactivos: Medio PDA, Solución de Tween
Método
Se utilizaron plántulas de Tomate Río Grande (HORTUS), cuya siembra se realizó en bandejas speedling de 200 celdillas; con un sustrato compuesto por una mezcla de tierra de cultivo y sustrato para almacigo en proporción 1: 1. La siembra se realizó el día 02 de octubre; el trasplante a bolsas de 200 cm3 se realizó cuando las plántulas tuvieron 4 a 5 hojas verdaderas el día 26 de Noviembre. Las bolsas contenían sustrato para el crecimiento de las plantas compuesto por tierra de cultivo suelo y turba en una relación 1 : 1, el cual fue esterilizado dos veces mediante autoclave a 121 º C y 15 libras de presión por media hora.
Sembramos las semillas de Tomate (Río Grande):
-
√ Colocamos 10gr de sustrato para almácigo y 3 semillas de tomate Río Grande (Hortus) en cada celdilla de la bandeja de germinación (speedling).
-
√ Posteriormente se incuba en la cámara de germinación con una temperatura de 21.8ºC y humedad de 69%.
-
√ Se riega dejando un día con agua destilada estéril para mantener el cultivo totalmente aséptico.
-
√ Las plántulas tenían tallo germinativo a los 3 días de sembradas. Se traspasan a bolsas de cultivo, para ello utilizamos una mezcla de tierra de cultivo y sustrato para almacigo previamente autoclavados para mantener la asepsia.
-
√ Trasladamos las plántulas al invernadero.
Reactivación de Trichoderma sp.
-
√ Se sembró Trichoderma sp. (Cepa del Laboratorio de Biotecnología) en medio PDA líquido, para reactivar el hongo.
Cepas de Fusarium solani, Trichoderma sp y Trichoderma viride
-
√ Estas cepas están sembradas en medio PDA.
Confrontación in vitro de Fusarium sp. frente a Trichoderma sp. y Trichoderma viride
Las acciones del antagonista se comprobaron, haciéndolo crecer en medio PDA. Los inóculos se obtuvieron de las cepas sembradas en las placas, tomando discos de 5 mm de diámetro para las confrontaciones, se siembran en placas Petri con medio PDA y en puntos equidistantes respecto al antagonista, mediante toques superficiales del medio de cultivo con un asa. Las placas se incuban en estufa a 25ºC.
Realizamos la prueba de antibiosis:
Esta prueba es necesaria para verificar la eficiencia de de Trichoderma sp sobre Fusarium sp y Trichoderma viride sobre Fusarium sp in vitro
Preparación de la suspensión de esporas:
Para desprender las esporas se utiliza la solución TWEEN, agregando lOml a los tubos con cepa de T. viride, T.sp y Fusarium sp. respectivamente, se agita por unos minutos para desprender el mayor número de esporas, traspasándolo a un tubo estéril y procedemos al cálculo del número de esporas mediante la siguiente fórmula:
Nº CONIDIAS/ml = Nº CONIDIAS x 5 x 104
Evaluación del efecto antagónico de Trichoderma sp. sobre Fusarium sp. en Tomate Río Grande (Hortus)
Para este efecto, se extrajeron las plántulas de las bandejas, se lavaron las raíces, para luego ser cortadas con un bisturí, con el fin de favorecer la infección por parte del patógeno. La cepa de Trichoderma sp y el producto comercial Trichoderma viride fueron aplicados a las raíces de las plantas y al hoyo de plantación en las bolsas al momento del trasplante. Para lograr esto, se asperjó 5 m1 de una suspensión de conidias de ambos biocontroladores tanto a las raíces como al hoyo de plantación. Del mismo modo, el fungicida Benomilo fue aplicado sumergiendo las raíces de las plántulas por 5 minutos en una suspensión del fungicida (0,6 g benomilo L-1) y posteriormente trasplantadas.
Para los tratamientos que consideraban benomilo y el biocontrolador o Trichodex en conjunto se procedió primero a sumergir las raíces en el fungicida por 5 minutos y posteriormente se asperjó el biocontrolador de la forma anteriormente descrita.
Para el caso de las plantas testigo, éstas fueron trasplantadas directamente a las bolsas.
La totalidad de las bolsas fueron puestas en el invernadero, donde la temperatura máxima fluctuó entre 20 y 35° c desde el inicio hasta concluido el ensayo.
Resultados y Discusión
Trichoderma sp. y Trichoderma viride demostraron un claro efecto antagónico contra Fusarium sp. en los cultivos duales realizados previamente in vitro, en medio PDA, aumentando su actividad antifúngica mediante la secreción del enzima hidrolítica (β-l,3-glucanasa) (Ezziyyani 2004) y posiblemente otros, sobrecreciendo y reduciendo totalmente la colonia del patógeno.
La intensidad de inhibición de Fusarium sp., por Trichoderma in vitro varió según la especie de ya sea Trichoderma sp. o Trichoderma viride, fue intensa con Trichoderma viride (Fig. 2 y 4), mientras que con Trichoderma sp. (Fig. 1 y 3), la interacciones fue menos intensa o débil.
También se pudo observar una zona de inhibición progresiva, en parte por la mayor velocidad de crecimiento de T. viride, apareciendo después un marcado efecto hiperparasítico, que se manifiesta por la inhibición del crecimiento micelial no sólo por compartir el mismo sustrato sino también porque T. viride produce antibióticos y enzimas: (β-1,3-glucanasa, quitinasa, proteasa y celulasa) degradadores de la pared celular que juegan un importante papel en el micoparasitismo (Lorito et al. 1993,Papavizas & Lumsden 1980, Herrera et al .. 1999, Sid Ahmed et al. 2000).
Figura Nº 01
Trichoderma sp. frente al patógeno Fusarium sp.

Figura Nº 02
Trichodenna viride frente al patógeno Fusarium sp.

Figura Nº 03
Esporas de Trichodenna sp. frente al patógeno Fusarium sp.
Figura Nº 04
De esporas de Trichoderma viride frente al patógeno Fusarium sp.
Conclusión
La intensidad inhibitoria de Trichoderma sp y Trichoderma viride es muy grande en la confrontación in vitro con la aplicación de discos y de la solución de esporas, esto se debe a la mayor velocidad de crecimiento de ambos hongos sobre Fusarium sp, desarrollando un marcado efecto hiperparasítico, que se manifiesta por la inhibición del crecimiento micelial no sólo por compartir el mismo sustrato sino también porque Trichoderma sp y Trichoderma viride producen antibióticos y enzimas: (p-1,3- glucanasa, quitinasa, proteasa y celulasa) degradadores de la pared celular que juegan un importante papel en el micoparasitismo (Lorito et al. 1993, Papavizas & Lumsden 1980, Herrera et al. 1999, Sid Ahmed et al. 2000).
En nuestro estudio, los tratamientos que incluyeron a la formulación comercial Trichoderma viride, al fungicida Benomilo y a la mezcla de ambos, presentaron valores menores de incidencia de plantas enfermas. El tratamiento que combinó al fungicida con la cepa Trichoderma sp. presentó valores elevados a los anteriores, fluctuando entre el 30 a 100%. Esta situación confirma las conclusiones de Dave et al. (citado por Cook, 1989).
Referencias Bibliográficas
Romero-Arenas, Ornar; Huerta Lara, Manuel; Damián Huato, Miguel Angel; Domínguez Hernández, Francisco; Arellano Victoria, Daniel Alfonso. Características de Trichoderma harzianum, como agente limitante en el cultivo de hongos comestibles Revista Colombiana de Biotecnología, Vol. XI, Núm. 2, diciembre, 2009, pp. 143-151 Universidad Nacional de Colombia. Colombia
Ezziyyani, Mohammed; Pérez Sánchez, Consuelo; Sid Ahmed, Ahmed, Requena, María Emilia & Candela, María Emilia. Trichoderma harzianum como biofungicida para el biocontrol de Phytophthora capsici en plantas de pimiento (Capsicum annuum L.). Departamento de Biología Vegetal, Facultad de Biología, Universidad de Murcia, Campus de Espinardo, 30100 Espinardo, Murcia, España.
Mónaco, C; Nico, A; Rollán, M; Urrutia, M. Efecto «in vitro» de dos fungicidas sobre la micoflora antagonista al tizón temprano del tomate Facultad de Ciencias Agrarias y Forestales. Universidad Nacional de La Plata. Buenos Aires. Argentina. La Plata, Buenos Aires. Argentina.
García, Rosaima; RIERA, Ramón; Zambrano, Carlos & Gutiérrez, Luis. Desarrollo de un fungicida biológico a base de una cepa del hongo Trichoderma harzianum proveniente de la región andina venezolana. Instituto de Investigaciones de Sanidad Vegetal. Ciudad de La Habana, Cuba. Fitosanidad, vol. 1 O, núm. 2, junio, 2006, pp. 115-121.
Tovar Castaño, Julio Cesar. Evaluación de la capacidad antagonista "In vitro" de aislamientos en Trichoderma spp. frente al hongo fitopatógeno Rhizoctonia solani. Pontificia Universidad Javeriana. Facultad de Ciencias. Bogotá 2008.
Notas de autor